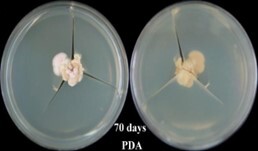
高醫柯宏慧

﹤Biotech & Biomed Innovation﹥Diaprothe Endophyte Extract – UV Protection & Brightening Solution
Kaohsiung Medical University / Prof. Horng-Huey Ko
Pain Points Solved
- Long-term exposure to ultraviolet (UV) radiation can lead to skin hyperpigmentation, dryness, inflammation, and photoaging; however, existing ingredients often provide limited efficacy or are associated with skin irritation.
- There is a lack of natural, safe, and effective ingredients that can simultaneously protect against UV-induced damage and reduce melanin production.
Technology Introduction
The present invention provides the utilization of Diaporthe caulivora extract for formulating a composition that combats ultraviolet damage and reduces hyperpigmentation. This novel application of an endophytic fungus isolated from the leaves of the Neolitsea daibuensis, a member of the Lauraceae family, holds significant value in the fields of cosmetics and biopharmaceuticals. The extract obtained from the endophytic fungus, under specific fermentation conditions, has been rigorously tested and demonstrated to possess anti-UV damage properties and the ability to mitigate skin pigmentation, thereby addressing issues such as skin dryness, inflammation, and photoaging resulting from excessive UV exposure. This innovative research contributes to the development of natural and effective ingredients for skincare and health products.

Figure 1.

Figure 2.
Application Examples
- The extract can be applied in whitening, sunscreen, and repair-oriented skincare products to effectively reduce UV-induced hyperpigmentation and skin aging.
- It can also serve as an active ingredient in biopharmaceutical or post-procedural recovery products, enhancing skin protection while providing soothing and restorative effects.
Related Links
None
Patent Name and Number
TW I755170
CN 202310317717.8、CN 5906956
Industry-Academia / Tech Transfer Partner
None
Honors and Awards
None
Technical Contact
Mr. Hung, Assistant Manager
Kaohsiung Medical University
Tel: +886 7-3121101 ext. 2360
Email: R121084@kmu.edu.tw


